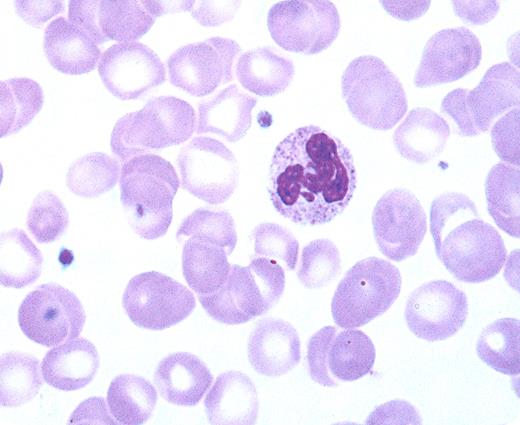

A 62-year-old man was diagnosed with breast cancer by a fine needle biopsy. The family history was negative for breast cancer. He and his wife had no children. When they were evaluated years earlier, he was noted to be infertile. Currently, the physical examination showed a lanky individual with mildly prominent hips, gynecomastia, and pea-sized firm testicles. The peripheral blood smear showed a small nodule of chromatin separated from the main nuclear lobe by a strand of chromatin (“drumsticks”) in approximately 3% of the polymorphonuclear leukocytes.
Drumsticks usually appear when two XX chromosomes are present. Women have drumsticks in 3% or more of the polymorphonuclear leukocytes. The active X chromosome is randomly distributed within nuclear lobes, but the inactive X preferentially appears in drumsticks. Typical drumsticks are rarely seen in normal men. Drumsticks should be differentiated from other nuclear appendages (sessile nodules, small clubs, small lobe, rackets) that may occasionally be seen in both sexes.
This patient was infertile, had small testicles, and drumsticks that suggested Klinefelter syndrome (XXY chromosomes). The chromosome analysis confirmed XXY. Patients with Klinefelter syndrome often have gynecomastia, low testosterone levels, and elevated FSH and LH. Studies also suggest that patients with Klinefelter syndrome have an increased tendency to develop breast cancer, the frequency of which is greater than that seen in normal (XY) males, but less frequency than in true females.
A 62-year-old man was diagnosed with breast cancer by a fine needle biopsy. The family history was negative for breast cancer. He and his wife had no children. When they were evaluated years earlier, he was noted to be infertile. Currently, the physical examination showed a lanky individual with mildly prominent hips, gynecomastia, and pea-sized firm testicles. The peripheral blood smear showed a small nodule of chromatin separated from the main nuclear lobe by a strand of chromatin (“drumsticks”) in approximately 3% of the polymorphonuclear leukocytes.
Drumsticks usually appear when two XX chromosomes are present. Women have drumsticks in 3% or more of the polymorphonuclear leukocytes. The active X chromosome is randomly distributed within nuclear lobes, but the inactive X preferentially appears in drumsticks. Typical drumsticks are rarely seen in normal men. Drumsticks should be differentiated from other nuclear appendages (sessile nodules, small clubs, small lobe, rackets) that may occasionally be seen in both sexes.
This patient was infertile, had small testicles, and drumsticks that suggested Klinefelter syndrome (XXY chromosomes). The chromosome analysis confirmed XXY. Patients with Klinefelter syndrome often have gynecomastia, low testosterone levels, and elevated FSH and LH. Studies also suggest that patients with Klinefelter syndrome have an increased tendency to develop breast cancer, the frequency of which is greater than that seen in normal (XY) males, but less frequency than in true females.
Many Blood Work images are provided by the ASH IMAGE BANK, a reference and teaching tool that is continually updated with new atlas images and images of case studies. For more information or to contribute to the Image Bank, visit www.ashimagebank.org.